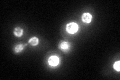
YLR335W
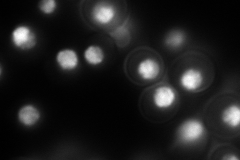
YLR335W
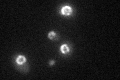
YLR335W

View description
Nucleoporin involved in nucleocytoplasmic transport, binds to either the nucleoplasmic or cytoplasmic faces of the nuclear pore complex depending on Ran-GTP levels; also has a role in chromatin organization
Localization:
Intensity:
Fold change:
Significance:
-
C’ GFP library in SD
nuclear periphery64.11 -
N' NOP1pr-GFP in SD
punctate,nucleus206.456 -
N' TEF2pr-mCherry in SD

cytosol208.428 -
N' NATIVEpr-GFP in SD

punctate,nuclear periphery85.3048 -
N' TEF2pr-VC and Cyto-VN in SD

punctate,nucleus62.5783 -
C’ GFP library in SD+DTT

nuclear periphery61.760.96No -
C’ GFP library in SD+H2O2

nuclear periphery74.311.15No -
C’ GFP library in Starvation Media
nuclear periphery60.490.94No -
C’ GFP library on the background of Pup2-DaMP

N/A -
C’ GFP library on the background of CCT mutant

N/A0N/AYes
